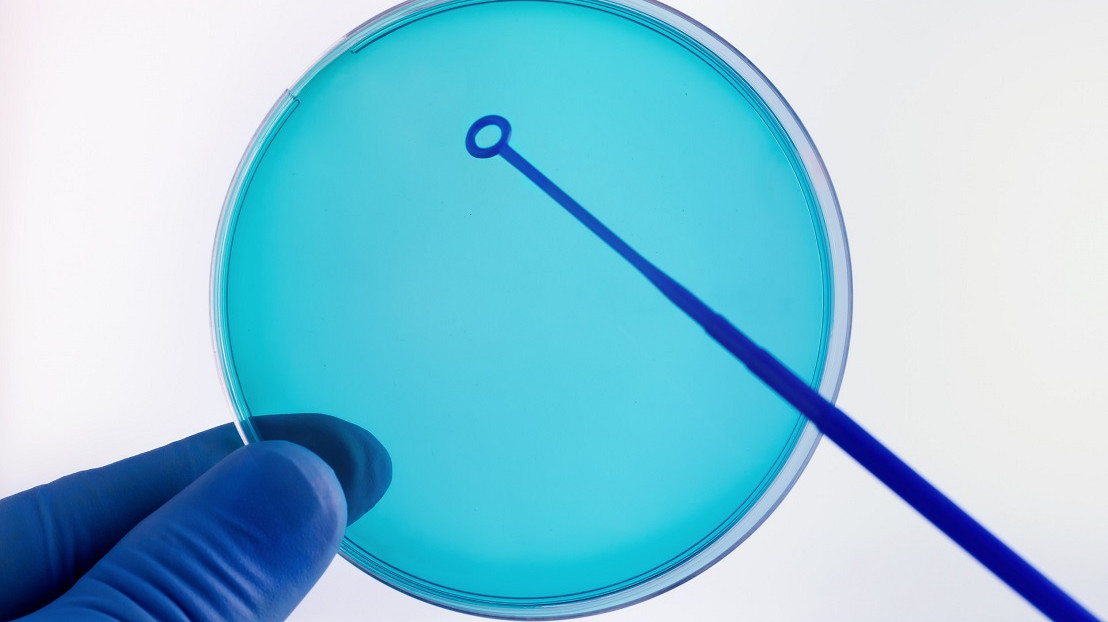

Более 60% региональных минздравов прекратили раскрывать данные об эффективности программ ЭКО
Только 23 региона России представили редакции портала «ПроДокторов» статистические данные об эффективности программ экстракорпорального оплодотворения (ЭКО). Таким образом, на запрос СМИ в ноябре 2025 года не ответили более 60% минздравов субъектов. Некоторые из них заявили о закрытом характере этой информации.
Ранее аналогичный запрос был направлен в феврале 2025 года. Тогда отчеты прислали 56 региональных минздравов, причем многие из них отметили, что информация об эффективности применения вспомогательных репродуктивных технологий (ВРТ) в отчетном году, собранная в начале следующего года, не показательна.
Согласно полученным в ноябре данным, средняя эффективность процедур ЭКО в России (привели к беременности) достигла в 2024 году 33%. Выше общероссийского показатели в Брянской области (50,5%), Камчатском крае (46,97%), Ростовской области (45,16%), Ставропольском крае (43,6%), Волгоградской (42,33%), Амурской (41,64%), Новгородской (41,2%) областях.
Среди регионов, предоставивших данные об эффективности ЭКО в относительных цифрах, наибольшую эффективность продемонстрировали Смоленская область (38%), Краснодарский край (34%), Тюменская (30%) и Московская (25–30%) области.
На прошлой неделе Ассоциация клиник ВРТ предложила государству активнее сотрудничать с частным сектором в вопросах лечения бесплодия и не снижать его участие в госпрограммах, писал «МВ». По данным организации, на долю негосударственных медцентров приходится 72% всех циклов ЭКО в России.
















Нет комментариев
Комментариев: